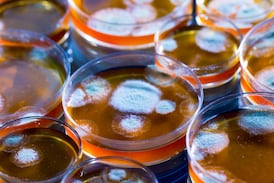
La penicilina y el poder de Estados Unidos

Los cambios en firmas multinacionales, de servicios corporativos y tecnológicos implican oportunidades para Costa Rica, así como retos y una estrategia común de todos los ‘actores’ locales
La expectativa club Herediano es que el nuevo Eladio Rosabal Cordero abra sus puertas a mediados de este 2026.
La Autoridad Reguladora de los Servicios Públicos (Aresep) ubicó territorios con rezagos en agua, electricidad, gas y transporte. El análisis clasifica los cantones en tres niveles de afectación y servirá para priorizar acciones regulatorias, afirma la institución.
Este viernes, el promedio ponderado del tipo de cambio en el Monex cerró en ¢481,78